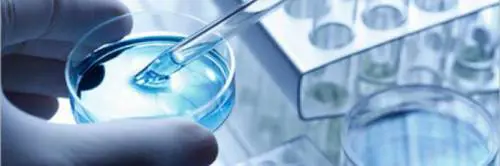

L'efficacia di questo regime alimentare è stata testata da uno studio olandese apparso su 'Nature Communications'

L'efficacia di questo regime alimentare è stata testata da uno studio olandese apparso su 'Nature Communications'

Slick Woods è malata di cancro e si sta sottoponendo a svariati cicli di chemioterapia: la modella della linea FENTY di Rihanna è decisa a vincere questa battaglia

Svolta vicina per proteggere i capelli dagli effetti della chemio. Ricercatori britannici hanno sfruttato le proprietà di una nuova classe di farmaci che bloccano la divisione cellulare senza promuovere ulteriori effetti tossici
La moglie di Radja Nainggolan sta lottando contro un tumore e posta una foto su Instagram in cui racconta l’inizio della chemioterapia: lo scatto sommerso di like e commenti d’incoraggiamento

In Florida, i genitori di un bambino affetto da leucemia linfoblastica rifiutano le terapie tradizionali e scelgono di curarlo con tisane alla cannabis. Per questo motivo, un giudice del tribunale locale ha affidato la custodia temporanea del bambino ai nonni materni

Le immagini più belle e forti di Selma Blair: attrice molto amata e ora al centro dell'attenzione perché colpita da sclerosi multipla

Selma Blair provocatoria con uno scatto pubblicato su Instagram: l'attrice mostra il lato B nudo, coprendo le parti intime con una singolare borsetta

L’attrice, che combatte da un anno contro il cancro, posta una foto in cui si dice “felice ed emozionata” perché “dopo mesi e mesi comincio a riconoscermi”

Una bambina di dodici anni, originaria di Perth (Australia) ha sconfitto un cancro al cervello in fase terminale grazie all'intervento di un temerario neurochirurgo

A Casalnuovo il contributo per l'acquisto di parrucche a favore di donne sottoposte a chemioterapia. Nei prossimi giorni la domanda sul sito del Comune
